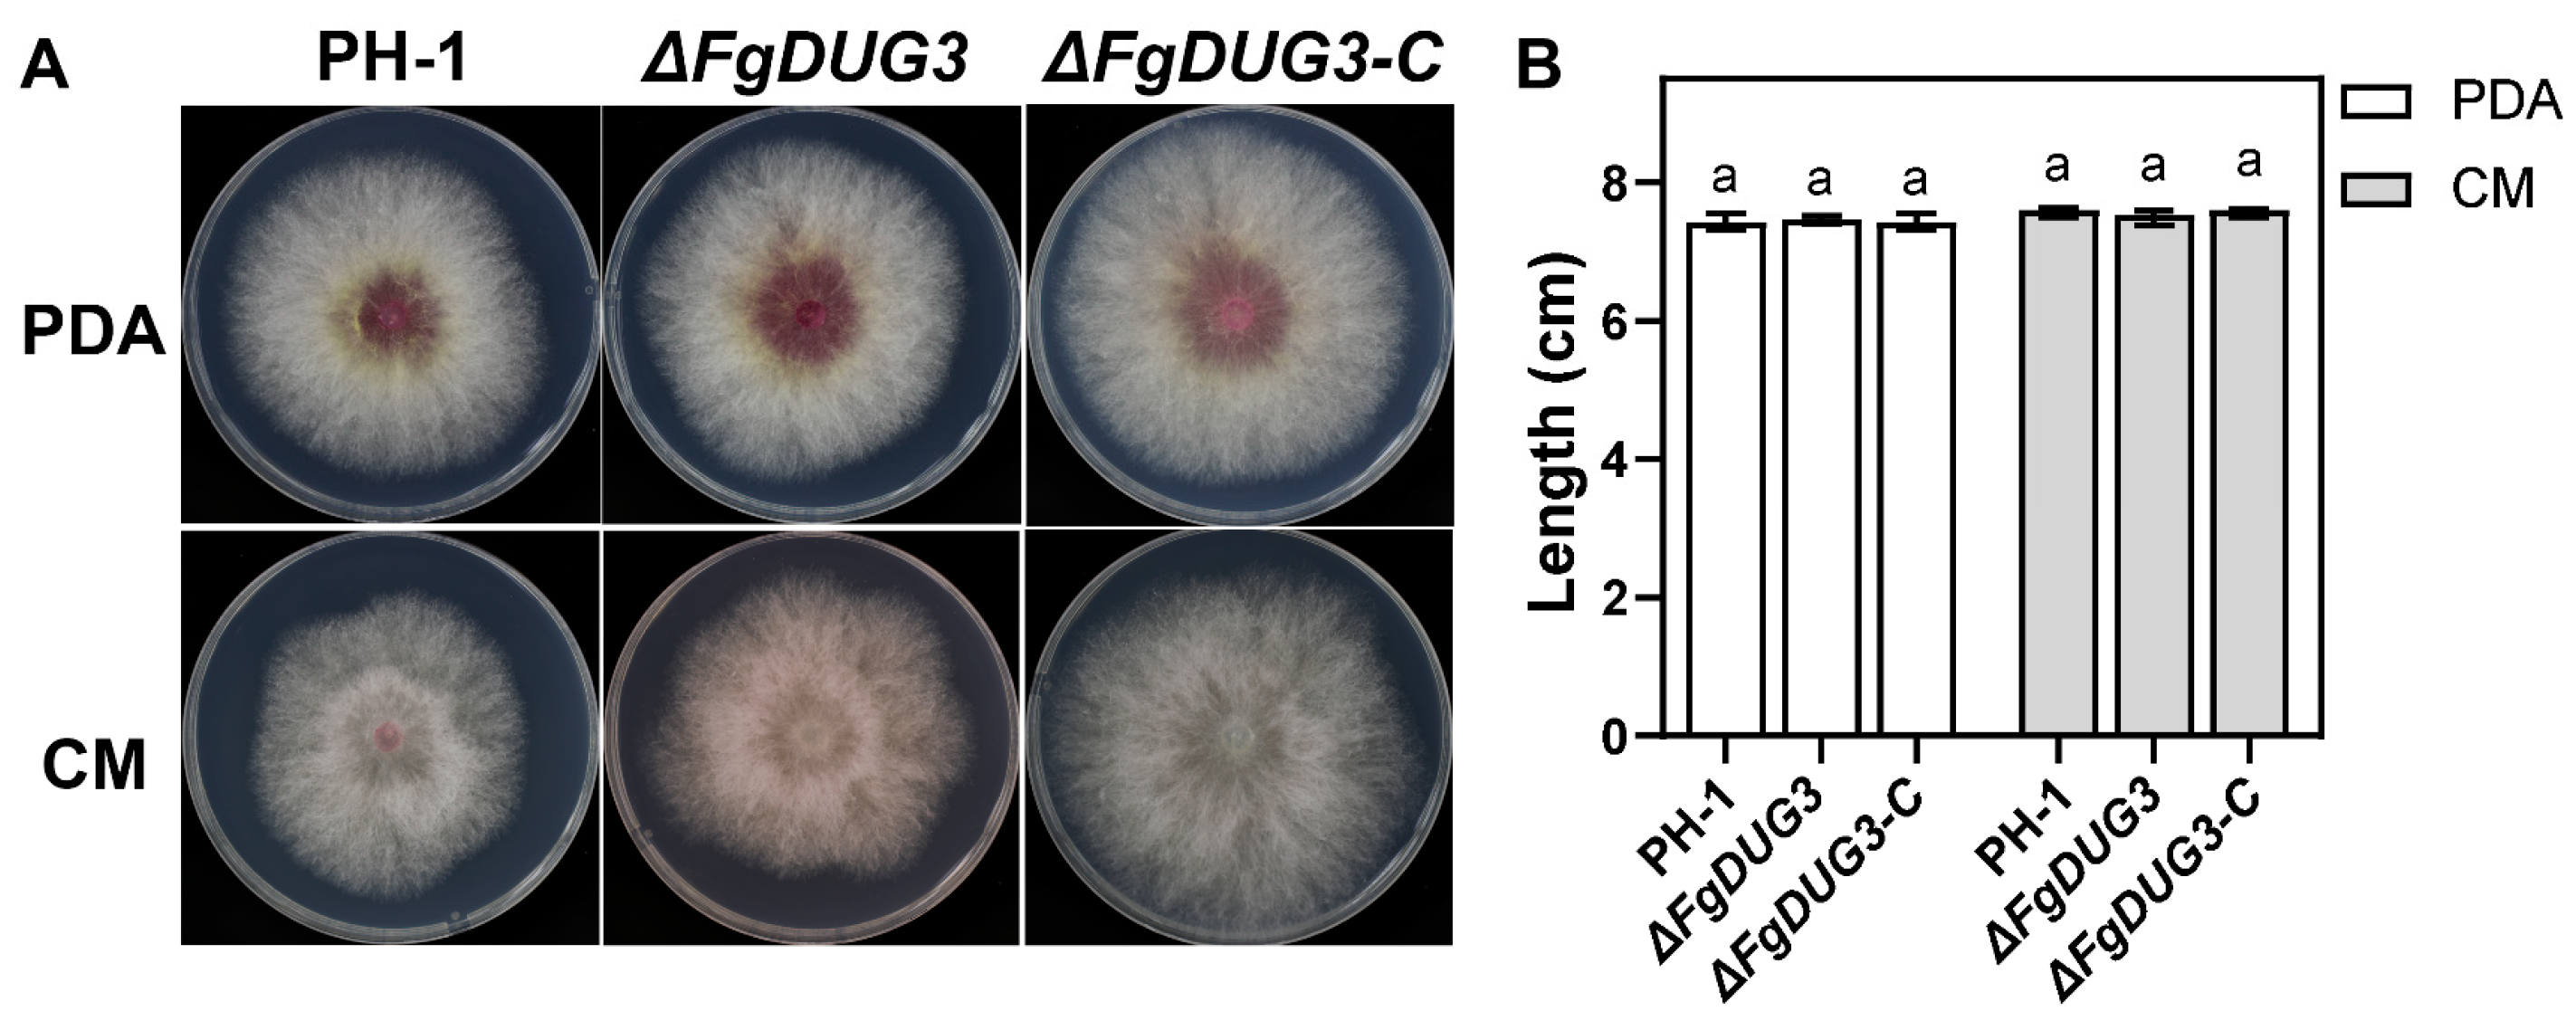

A Class II Glutamine Amidotransferase FgDUG3 Is Involved in the Differentiation and Full Virulence of Fusarium graminearum
Abstract
1. Introduction
2. Materials and Methods
2.1. Fungal Strains and Culture Conditions
2.2. Bioinformatic Analysis
2.3. Target Gene Deletion and Complementation
2.4. Characterization of Phenotypes
2.5. Sexual Reproduction
2.6. Pathogenicity Assay
2.7. Transcriptomic Analysis
3. Results
3.1. Phylogenetic Analysis of DUG3 Proteins
3.2. Generation of FgDUG3 Deletion Mutants
3.3. FgDUG3 Is Dispensable for Mycelial Growth
3.4. FgDUG3 Is Involved in Asexual Reproduction
3.5. FgDUG3 Is Associated with Germ Tube Development
3.6. FgDUG3 Is Required for Full Virulence
3.7. Differentially Expressed Genes Regulated by FgDUG3
4. Discussion
5. Conclusions
Author Contributions
Funding
Institutional Review Board Statement
Informed Consent Statement
Data Availability Statement
Acknowledgments
Conflicts of Interest
Abbreviations
| DON | Deoxynivalenol |
| GSH | Glutathione |
| ROS | Reactive oxygen species |
| PDA | Potato dextrose agar |
| DEGs | Differentially expressed genes |
| CM | Complete agar |
| CMC | Carboxymethyl cellulose |
Appendix A
| Primer | Sequence (5′-3′) |
|---|---|
| FgDUG3-1F | AGTGACGCCAGCAGGATA |
| Hyg-FgDUG3-1R | TTGACCTCCACTAGCTCCAGCCAAGCCTGATTGCGTGTTACGGAT |
| FgDUG3-2F | TATGGATCGAGGCAAGGT |
| Hyg-FgDUG3-1R | GAATAGAGTAGATGCCGACCGCGGGTT |
| FgDUG3-2R | CCTGTGATGGAAAAGAGG |
| FgDUG3-5F | ATGTGCCGTTTTCTGGTG |
| FgDUG3-6R | TCACCCCGCATGGGAGGC |
| HYG/F | GGCTTGGCTGGAGCTAGTGGAGGTCAA |
| HYG/R | AACCCGCGGTCGGCATCTACTCTATTC |
| HY/R | GTATTGACCGATTCCTTGCGGTCCGAA |
| YG/F | GATGTAGGAGGGCGTGGATATGTCCT |
| H852 | TTCCTCCCTTTATTTCAGATTCAA |
| H850 | ATGTTGGCGACCTCGTATTGG |
| A1 | A2 | A3 | B1 | B2 | B3 | |
|---|---|---|---|---|---|---|
| Total reads | 62,670,288(100.00%) | 65,215,212(100.00%) | 64,694,700(100.00%) | 75,654,640(100.00%) | 32,819,352(100.00%) | 62,749,358(100.00%) |
| Total mapped | 59,858,562(95.51%) | 61,760,765(94.70%) | 63,100,844(97.54%) | 40,018,705(52.90%) | 10,521,595(32.06%) | 57,468,385(91.58%) |
| Mutiple mapped | 265,266(0.42%) | 233,445(0.36%) | 270,593(0.42%) | 126,563(0.17%) | 835,181(2.54%) | 206,012(0.33%) |
| Uniquely mapped | 59,593,296(95.09%) | 61,527,320(94.35%) | 62,830,251(97.12%) | 39,892,142(52.73%) | 9,686,414(29.51%) | 57,262,373(91.26%) |
| Read-1 mapped | 29,879,586(47.68%) | 30,870,888(47.34%) | 31,526,988(48.73%) | 20,012,291(26.45%) | 4,856,115(14.80%) | 28,732,486(45.79%) |
| Read-2 mapped | 29,713,710(47.41%) | 30,656,432(47.01%) | 31,303,263(48.39%) | 19,879,851(26.28%) | 4,830,299(14.72%) | 28,529,887(45.47%) |
| Reads map to ‘+’ | 29,786,332(47.53%) | 30,753,179(47.16%) | 31,403,465(48.54%) | 19,941,079(26.36%) | 4,840,809(14.75%) | 28,626,222(45.62%) |
| Reads map to ‘-’ | 29,806,964(47.56%) | 30,774,141(47.19%) | 31,426,786(48.58%) | 19,951,063(26.37%) | 4,845,605(14.76%) | 28,636,151(45.64%) |
| Non-splice reads | 45,069,390(71.92%) | 46,582,022(71.43%) | 48,344,264(74.73%) | 30,475,976(40.28%) | 7,369,629(22.46%) | 43,701,686(69.64%) |
| Splice reads | 14,523,906(23.18%) | 14,945,298(22.92%) | 14,485,987(22.39%) | 9,416,166(12.45%) | 2,316,785(7.06%) | 13,560,687(21.61%) |
| Reads mapped in proper pairs | 58,975,354(94.10%) | 60,862,436(93.33%) | 62,138,088(96.05%) | 39,439,416(52.13%) | 9,576,482(29.18%) | 56,594,788(90.19%) |
| A1 | A2 | A3 | B1 | B2 | B3 | |
|---|---|---|---|---|---|---|
| NC_026474.1 | 20,227,948 | 20,774,447 | 21,217,351 | 12,787,728 | 3,032,299 | 18,272,007 |
| NC_026475.1 | 13,050,356 | 13,511,959 | 13,890,967 | 9,574,912 | 2,153,423 | 13,694,690 |
| NC_026476.1 | 13,039,232 | 13,411,780 | 13,738,661 | 8,712,263 | 2,042,997 | 12,571,361 |
| NC_026477.1 | 13,265,090 | 13,819,345 | 13,970,199 | 8,810,227 | 2,123,575 | 12,715,866 |
| NW_001837897.1 | 1630 | 1603 | 1674 | 773 | 186 | 1081 |
| NW_001837898.1 | 0 | 0 | 1 | 0 | 0 | 0 |
| NW_001837899.1 | 5 | 4 | 13 | 0 | 0 | 0 |
| NW_001837900.1 | 7 | 5 | 4 | 8 | 205 | 0 |
| NW_001837902.1 | 4075 | 3674 | 4277 | 1651 | 510 | 2433 |
| NW_001837903.1 | 80 | 57 | 92 | 80 | 3951 | 69 |
| NW_001837904.1 | 2 | 19 | 17 | 4 | 334 | 1 |
| NW_001837905.1 | 29 | 12 | 40 | 0 | 21 | 0 |
| NW_001837906.1 | 7 | 6 | 10 | 3 | 451 | 12 |
Appendix B


References
- Bekele, B.; Dawit, W. Review on the status and management strategies of Fusarium head blight (Fusarium graminearum) of wheat. Int. J. Agric. Sustain. 2018, 4, 2348–3997. [Google Scholar]
- Goswami, R.S.; Kistler, H.C. Heading for disaster: Fusarium graminearum on cereal crops. Mol. Plant Pathol. 2004, 5, 515–525. [Google Scholar] [CrossRef] [PubMed]
- Valverde-Bogantes, E.; Bianchini, A.; Herr, J.R.; Rose, D.J.; Wegulo, S.N. Hallen-Adams, H.E. Recent population changes of Fusarium head blight pathogens: Drivers and implications. Can. J. Plant Pathol. 2020, 42, 315–329. [Google Scholar] [CrossRef]
- Akinmoladun, O.F.; Fon, F.N.; Nji, Q.; Adeniji, O.O.; Tangni, E.K.; Njobeh, P.B. Multiple mycotoxin contamination in livestock feed: Implications for animal Health, productivity, and food safety. Toxins 2025, 17, 365. [Google Scholar] [CrossRef]
- Kamle, M.; Mahato, D.K.; Gupta, A.; Pandhi, S.; Sharma, B.; Dhawan, K.; Vasundhara; Mishra, S.; Kumar, M.; Tripathi, A.D. Deoxynivalenol: An overview on occurrence, chemistry, biosynthesis, health effects and its detection, management, and control strategies in food and feed. Microbiol. Res. 2022, 13, 292–314. [Google Scholar] [CrossRef]
- Penninckx, M.J.; Elskens, M.T. Metabolism and functions of glutathione in micro-organisms. Adv. Microb. Physiol. 1993, 34, 239–301. [Google Scholar] [PubMed]
- Gila, B.C.; Moon, H.; Antal, K.; Hajdu, M.; Kovács, R.; Jónás, A.P.; Pusztahelyi, T.; Yu, J.-H.; Pócsi, I.; Emri, T. The DUG pathway governs degradation of intracellular glutathione in Aspergillus nidulans. Appl. Environ. Microbiol. 2021, 87, e01321-20. [Google Scholar] [CrossRef]
- Georgiou-Siafis, S.K.; Tsiftsoglou, A.S. The key role of GSH in keeping the redox balance in mammalian cells: Mechanisms and significance of GSH in detoxification via formation of conjugates. Antioxidants 2023, 12, 1953. [Google Scholar] [CrossRef]
- Jozefczak, M.; Remans, T.; Vangronsveld, J.; Cuypers, A. Glutathione is a key player in metal-induced oxidative stress defenses. Int. J. Mol. Sci. 2012, 13, 3145–3175. [Google Scholar] [CrossRef]
- Di Giulio, R.T.; Meyer, J.N. Reactive oxygen species and oxidative stress. In The Toxicology of Fishes; CRC Press: Boca Raton, FL, USA, 2008; Volume 10. [Google Scholar] [CrossRef]
- Park, J.; Han, J.W.; Lee, N.; Kim, S.; Choi, S.; Lee, H.-H.; Kim, J.-E.; Seo, Y.-S.; Choi, G.J.; Lee, Y.-W. Sulfur metabolism-mediated fungal glutathione biosynthesis is essential for oxidative stress resistance and pathogenicity in the plant pathogenic fungus Fusarium graminearum. mBio 2024, 15, e02401-23. [Google Scholar] [CrossRef]
- Wangsanut, T.; Pongpom, M. The role of the glutathione system in stress adaptation, morphogenesis and virulence of pathogenic fungi. Int. J. Mol. Sci. 2022, 23, 10645. [Google Scholar] [CrossRef] [PubMed]
- Bachhawat, A.K.; Kaur, A. Glutathione degradation. Antioxid. Redox Signal. 2017, 27, 1200–1216. [Google Scholar] [CrossRef]
- Kumar, C.; Sharma, R.; Bachhawat, A.K. Utilization of glutathione as an exogenous sulfur source is independent of γ-glutamyl transpeptidase in the yeast Saccharomyces cerevisiae: Evidence for an alternative gluathione degradation pathway. FEMS Microbiol. Lett. 2003, 219, 187–194. [Google Scholar] [CrossRef]
- Ganguli, D.; Kumar, C.; Bachhawat, A.K. The alternative pathway of glutathione degradation is mediated by a novel protein complex involving three new genes in Saccharomyces cerevisiae. Genetics 2007, 175, 1137–1151. [Google Scholar] [CrossRef]
- Reza, M.H.; Sanyal, K. Defective in utilizing glutathione 3, DUG3, is required for conidiation and host infection in the rice blast fungus Magnaporthe oryzae. Micropubl. Biol. 2022, 2022. [Google Scholar] [CrossRef]
- Sevastos, A.; Labrou, N.; Flouri, F.; Malandrakis, A. Glutathione transferase-mediated benzimidazole-resistance in Fusarium graminearum. Pestic. Biochem. Physiol. 2017, 141, 23–28. [Google Scholar] [CrossRef]
- Fu, Z.; Chen, Y.; Cai, G.; Peng, H.; Wang, X.; Li, P.; Gu, A.; Li, Y.; Ma, D. An antisense long non-coding RNA, LncRsn, is involved in sexual reproduction and full virulence in Fusarium graminearum. J. Fungi 2024, 10, 692. [Google Scholar] [CrossRef]
- Li, P.; Fu, Z.; Wang, M.; Yang, T.; Li, Y.; Ma, D. Functional Characterization of FgAsp, a Gene Coding an Aspartic Acid Protease in Fusarium graminearum. J. Fungi 2024, 10, 879. [Google Scholar] [CrossRef]
- Cai, L.; Xu, X.; Dong, Y.; Jin, Y.; Rashad, Y.M.; Ma, D.; Gu, A. Roles of Three FgPel Genes in the Development and Pathogenicity Regulation of Fusarium graminearum. J. Fungi 2024, 10, 666. [Google Scholar] [CrossRef] [PubMed]
- Fu, J.; Zhang, X.; Chen, X.; Yin, Y.; Ma, Z. Serine O-acetyltransferase is important, but not essential for cysteine–methionine synthesis in Fusarium graminearum. World J. Microbiol. Biotechnol. 2014, 30, 1219–1228. [Google Scholar] [CrossRef] [PubMed]
- Cao, S.; Jiang, W.; Shu, Y.; Li, W.; Zhang, Y.; Zhang, A.; Chen, H. UDP-galactopyranose mutase mediates cell wall integrity, polarity growth, and virulence in Fusarium graminearum. Appl. Environ. Microbiol. 2023, 89, e01235-22. [Google Scholar] [CrossRef]
- Chen, A.; Ju, Z.; Wang, J.; Wang, J.; Wang, H.; Wu, J.; Yin, Y.; Zhao, Y.; Ma, Z.; Chen, Y. The RasGEF FgCdc25 regulates fungal development and virulence in Fusarium graminearum via cAMP and MAPK signalling pathways. Environ. Microbiol. 2020, 22, 5109–5124. [Google Scholar] [CrossRef] [PubMed]
- Zhang, C.; Wang, Y.; Wang, J.; Zhai, Z.; Zhang, L.; Zheng, W.; Zheng, W.; Yu, W.; Zhou, J.; Lu, G. Functional characterization of Rho family small GTPases in Fusarium graminearum. Fungal Genet. Biol. 2013, 61, 90–99. [Google Scholar] [CrossRef]
- Fu, T.; Han, J.-H.; Shin, J.-H.; Song, H.; Ko, J.; Lee, Y.-H.; Kim, K.-T.; Kim, K.S. Homeobox transcription factors are required for fungal development and the suppression of host defense mechanisms in the Colletotrichum scovillei-pepper pathosystem. mBio 2021, 12, e0162021. [Google Scholar] [CrossRef]
- Massière, F.; Badet-Denisot, M.-A. The mechanism of glutamine-dependent amidotransferases. Cell. Mol. Life Sci. CMLS 1998, 54, 205–222. [Google Scholar] [CrossRef]
- Walker, G.M.; White, N.A. Introduction to fungal physiology. In Fungi: Biology and Applications; Wiley: Hoboken, NJ, USA, 2017; pp. 1–35. [Google Scholar]
- Calvo, A.M.; Wilson, R.A.; Bok, J.W.; Keller, N.P. Relationship between secondary metabolism and fungal development. Microbiol. Mol. Biol. Rev. 2002, 66, 447–459. [Google Scholar] [CrossRef]
- Calvo, A.M.; Cary, J.W. Association of fungal secondary metabolism and sclerotial biology. Front. Microbiol. 2015, 6, 62. [Google Scholar] [CrossRef] [PubMed]
- Kishorekumar, R.; Bulle, M.; Wany, A.; Gupta, K.J. An overview of important enzymes involved in nitrogen assimilation of plants. In Nitrogen Metabolism in Plants: Methods and Protocols; Humana: New York, NY, USA, 2019; pp. 1–13. [Google Scholar]
- Kim, W.; Kim, D.-W.; Wang, Z.; Liu, M.; Townsend, J.P.; Trail, F. Transcription factor-dependent regulatory networks of sexual reproduction in Fusarium graminearum. mBio 2025, 16, e0303024. [Google Scholar] [CrossRef] [PubMed]
- Brauer, E.K.; Subramaniam, R.; Harris, L.J. Regulation and dynamics of gene expression during the life cycle of Fusarium graminearum. Phytopathology 2020, 110, 1368–1374. [Google Scholar] [CrossRef]
- Niu, G.; Yang, Q.; Liao, Y.; Sun, D.; Tang, Z.; Wang, G.; Xu, M.; Wang, C.; Kang, J. Advances in understanding Fusarium graminearum: Genes involved in the regulation of sexual development, pathogenesis, and deoxynivalenol biosynthesis. Genes 2024, 15, 475. [Google Scholar] [CrossRef]
- Steinberg, G.; Peñalva, M.A.; Riquelme, M.; Wösten, H.A.; Harris, S.D. Cell biology of hyphal growth. Microbiol. Spectr. 2017, 5. [Google Scholar] [CrossRef]
- Riquelme, M. Tip growth in filamentous fungi: A road trip to the apex. Annu. Rev. Microbiol. 2013, 67, 587–609. [Google Scholar] [CrossRef] [PubMed]
- Kershaw, M.J.; Talbot, N.J. Genome-wide functional analysis reveals that infection-associated fungal autophagy is necessary for rice blast disease. Proc. Natl. Acad. Sci. USA 2009, 106, 15967–15972. [Google Scholar] [CrossRef]
- Segal, L.M.; Wilson, R.A. Reactive oxygen species metabolism and plant-fungal interactions. Fungal Genet. Biol. 2018, 110, 1–9. [Google Scholar] [CrossRef]
- Divon, H.H.; Fluhr, R. Nutrition acquisition strategies during fungal infection of plants. FEMS Microbiol. Lett. 2007, 266, 65–74. [Google Scholar] [CrossRef]
- Chen, Y.; Kistler, H.C.; Ma, Z. Fusarium graminearum trichothecene mycotoxins: Biosynthesis, regulation, and management. Annu. Rev. Phytopathol. 2019, 57, 15–39. [Google Scholar] [CrossRef]
- Li, F.; Xu, W.; Zhao, S. Regulatory roles of metabolites in cell signaling networks. J. Genet. Genom. 2013, 40, 367–374. [Google Scholar] [CrossRef] [PubMed]
- Chandel, N.S. Signaling and metabolism. Cold Spring Harb. Perspect. Biol. 2021, 13, a040600. [Google Scholar] [CrossRef] [PubMed]

Disclaimer/Publisher’s Note: The statements, opinions and data contained in all publications are solely those of the individual author(s) and contributor(s) and not of MDPI and/or the editor(s). MDPI and/or the editor(s) disclaim responsibility for any injury to people or property resulting from any ideas, methods, instructions or products referred to in the content. |
© 2025 by the authors. Licensee MDPI, Basel, Switzerland. This article is an open access article distributed under the terms and conditions of the Creative Commons Attribution (CC BY) license (https://creativecommons.org/licenses/by/4.0/).
Share and Cite
Su, C.; Cao, P.; Dong, Y.; Xu, W.; Hao, C.; Gu, A.; Fang, Z.; Fu, T.; Ma, D. A Class II Glutamine Amidotransferase FgDUG3 Is Involved in the Differentiation and Full Virulence of Fusarium graminearum. J. Fungi 2025, 11, 763. https://doi.org/10.3390/jof11110763
Su C, Cao P, Dong Y, Xu W, Hao C, Gu A, Fang Z, Fu T, Ma D. A Class II Glutamine Amidotransferase FgDUG3 Is Involved in the Differentiation and Full Virulence of Fusarium graminearum. Journal of Fungi. 2025; 11(11):763. https://doi.org/10.3390/jof11110763
Chicago/Turabian StyleSu, Chang, Peina Cao, Ye Dong, Wenjie Xu, Chenjingzi Hao, Aiguo Gu, Zhengwu Fang, Teng Fu, and Dongfang Ma. 2025. "A Class II Glutamine Amidotransferase FgDUG3 Is Involved in the Differentiation and Full Virulence of Fusarium graminearum" Journal of Fungi 11, no. 11: 763. https://doi.org/10.3390/jof11110763
APA StyleSu, C., Cao, P., Dong, Y., Xu, W., Hao, C., Gu, A., Fang, Z., Fu, T., & Ma, D. (2025). A Class II Glutamine Amidotransferase FgDUG3 Is Involved in the Differentiation and Full Virulence of Fusarium graminearum. Journal of Fungi, 11(11), 763. https://doi.org/10.3390/jof11110763

